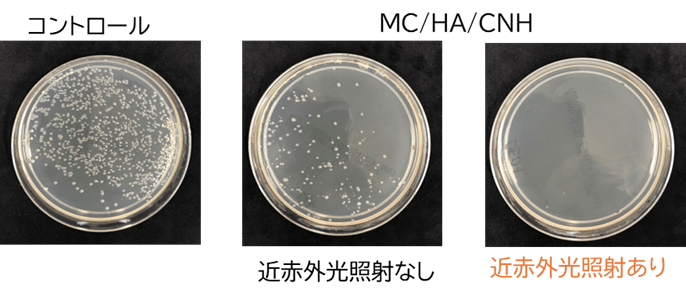
図2. A.a菌培養後の寒天培地。MC/HA/CNH混合なし(コントロール)と比較してMC/HA/CNH混合後は細菌のコロニーは減少し、さらに近赤外光照射するとコロニーは観察されなくなった。

【名城大学・北海道大学】インプラント周囲炎に対する光応答性ナノ複合体を開発
~インプラント周囲炎の新しい治療法への応用に期待~
ポイント
・炭素ナノ材料のカーボンナノホーン(CNH)を用いた光応答性ナノ複合体(MC/HA/CNH)を創製。
・MC/HA/CNHは近赤外線照射によって抗菌効果が増強され、効果は長時間持続。
・歯科インプラント治療の問題であるインプラント周囲炎に対する治療法への応用に期待。
概要
北海道大学大学院歯学研究院の平田恵理助教、同大学の横山敦郎名誉教授、同大学大学院歯学院博士課程4年の小西大輔氏、同大学電子科学研究所の高野勇太准教授、名城大学大学院理工学研究科の湯田坂雅子特任教授らの研究グループは、インプラント周囲炎治療への応用を目指した光応答性ナノ複合体を開発しました。
歯科インプラント(*1)治療は失った歯を補綴(代替)する信頼できる方法ですが、近年、インプラントを喪失する原因であるインプラント周囲炎(*2)が深刻な問題として報告されています。そのため、インプラント周囲炎に対する効果的な治療法の開発が急務となっています。
カーボンナノホーン(CNH)(*3)は、光線力学効果(*4)を利用した薬物送達の担体として有望視されている炭素ナノ材料の一つです。研究グループは、CNHの特性である近赤外光(*5)による光線力学的作用を活かし、ミノサイクリン(MC)、ヒアルロン酸(HA)、CNHからなる光応答性ナノ複合体(MC/HA/CNH)を開発しました。
MC/HA/CNHは近赤外光照射によりMC単独よりも高い抗菌効果を示し、さらに、その効果は48時間の透析後も持続することが確認されました。すなわち、近赤外光が口腔粘膜を透過することから、光応答性ナノ複合体(MC/HA/CNH)によるインプラント周囲炎治療は、単回の薬剤投与後に光照射を繰り返すことで持続的な効果を得る可能性があります。本革新的アプローチは、将来のインプラント治療の発展に寄与するものと期待されます。
なお、本研究成果は2024年6月14日(金)公開のNanoscale誌に掲載されました。

背景
歯科インプラントは欠損歯に対する治療法として広く普及しつつあります。一方で、インプラント周囲組織(骨、粘膜)に細菌感染が進行すると、インプラント体と周囲骨組織との結合が失われ、インプラント体の脱落を引き起こすインプラント周囲炎が深刻な問題となっています。インプラント周囲炎に対する治療法は十分に確立されておらず、一般的にはインプラント体の清掃、表面の滑沢化、抗菌薬の局所投与などが行われています。しかし、インプラント体表面は微細な構造を有するため、その表面に一旦炎症が及ぶと、バイオフィルム(*6)を完全に除去することが困難です。また、抗菌薬の全身投与では副作用が危惧されます。そのため、効果的な治療法の開発が急務となっています。
研究手法
カーボンナノホーン(CNH)は、生体適合性が高く、様々な薬物を内部に包接できる構造をしている炭素ナノ材料です。また、近赤外光は組織透過性が高いことで知られており、CNHは近赤外光をよく吸収するという特徴があります。研究グループではこれまで、CNHを用いたインプラント材料などの研究開発を行い、骨との適合性が高いことを報告してきました。
CNHの上記のような特徴を利用して、抗菌薬であるミノサイクリン(MC)と複合し、近赤外光による抗菌作用増強を図りました。しかしながら、CNHとMCは強固に結合しているため、近赤外光を照射しても抗菌作用には変化がありませんでした。そこで、医療分野で幅広く利用されているヒアルロン酸(HA)とCNHを複合化し、MCを担持させたMC/HA/CNHを開発しました。このMC/HA/CNHにインプラント周囲炎の原因菌の一つであるA.a菌(*7)を播種し、近赤外光を照射した後の細菌生存率をMC単独の場合と比較しその有効性を検討しました。
研究成果
MC/HA/CNHの細菌生存率は近赤外光非照射下では約40%であり、MC単独(0.5 mg/mL相当濃度)とほぼ同等でした。しかし、近赤外光照射では生残細菌は検出されず(0%)、抗菌効果が大幅に増強されたことが確認されました。(図2、図3)
さらに、MC/HA/CNHを48時間透析した後でも、近赤外光照射下では生残細菌は検出されませんでした(図3)。これらの結果から、近赤外光照射によりCNHの光熱効果が引き起こされるとともに、CNH表面のHAからMC放出が促進され抗菌作用が増強されることが示されました。
今後への期待
少量の抗菌剤で持続的な効果を得ることは、薬剤耐性菌の出現抑制や副作用の低減に有利です。本研究で開発したMC/HA/CNHは、低濃度のMC投与で持続的な抗菌効果を得ることができます。すなわち、近赤外光とMC/HA/CNHを組み合わせたこの新しい治療法は、単回の薬剤投与後インプラント周囲粘膜を透過して近赤外光を複数回照射することにより、持続的な薬効を得ることを可能とします。この光応答性ナノ複合体は、今後のインプラント周囲炎治療やインプラント治療の発展に貢献することが期待されます。
謝辞
本研究は、⽂部科学省科学研究費助成事業(JP23K09266、JP21H01753、JP22K19609、JP24K1299)、花王Crescent awardの⽀援を受けて実施されました。
論文情報
【論文名】 Near-infrared Light-boosted Antimicrobial Activity of Minocycline/Hyaluronan/Carbon
Nanohorn Composite toward Peri-implantitis Treatments(インプラント周囲炎に対する近赤外光応答性ミノサイクリン/ヒアルロン酸/炭素ナノホーン複合体の開発)
【著者名】 小西大輔(1)、平田恵理(2)、高野勇太(3)、前田由佳利(2)、牛島夏未(2)、湯田坂雅子(4,5)、横山敦郎(2)
[(1)北海道大学大学院歯学院、(2)北海道大学大学院歯学研究院、(3)北海道大学電子科学研究所、(4)名城大学大学院理工学研究科、(5)産業技術総合研究所ナノ材料研究部門]
【雑誌名】 Nanoscale(ナノ材料の専門誌)
【DOI】 10.1039/D4NR01036A
【公表日】 2024年6月14日(金)(オンライン公開)
お問い合わせ先
北海道大学大学院歯学研究院 助教 平田恵理(ひらたえり)
TEL 011-706-4270 メール erieri@den.hokudai.ac.jp
配信元
北海道大学社会共創部広報課(〒060-0808 札幌市北区北8条西5丁目)
TEL 011-706-2610
FAX 011-706-2092
メール jp-press@general.hokudai.ac.jp
名城大学渉外部広報課(〒468-8502 名古屋市天白区塩釜口1丁目501番地)
TEL 052-838-2006
FAX 052-833-9494
メール koho@ccml.meijo-u.ac.jp
参考図

用語解説
*1 歯科インプラント … 欠損した歯の代わりに人工歯根を外科的に顎の骨に埋め込み、人工の歯を支えるもの。周囲の骨と直接結合することにより、強固な土台となる。
*2 インプラント周囲炎 … インプラント周囲組織(骨、粘膜)に生じた炎症。細菌感染が原因となることが多く、進行するとインプラント体と周囲骨組織との骨結合が喪失してインプラント体の脱落を引き起こす。
*3 カーボンナノホーン(CNH) … 飯島澄男博士らのグループが1998年に発見したカーボンナノチューブの一種。直径は2~5nm、長さ40~50nmで不規則な形状を持つ。数千本が寄り集まって直径100nm程度の球形集合体を形成している。金属触媒を用いることなく合成されるため生体適合性が高いことが報告されている。
*4 光線力学効果 … 光エネルギーを吸収した物質が熱や活性酸素種を発生し、周囲環境に作用する現象。
*5 近赤外光 … 可視光線より長い波長の光で、生体に対する透過性が高いことが知られている。
*6 バイオフィルム … 細菌が作り出す、細菌と食渣などの集合体のこと。インプラント表面に形成されるとインプラント周囲炎の原因となる。
*7 A.a菌 … Aggregatibacter actinomycetemcomitans. 歯周病やインプラント周囲炎の主要な原因菌の一つとされる。





